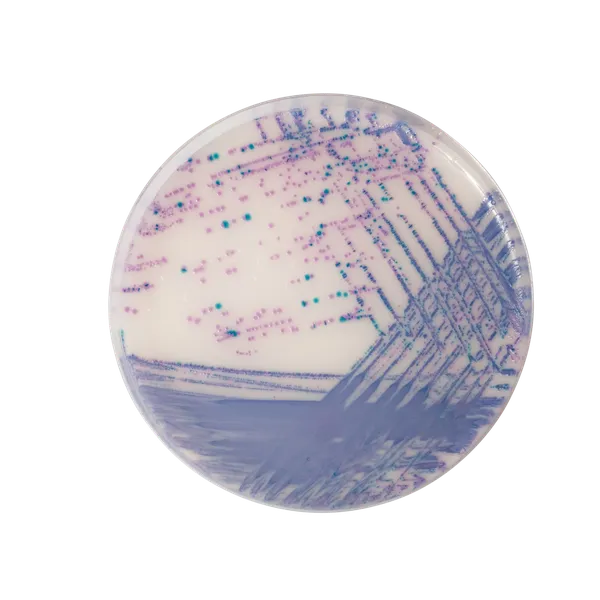
RambaQUICK™ Salmonella

Hình thái khuẩn lạc

Salmonella bao gồm S. typhi, S. paratyphi A và Salmonella dương tính với lactose
Màu tím nhạt
Hiệu năng
Hiệu năng
Từ báo cáo CDC về xu hướng bệnh truyền qua thực phẩm, 1996-2010:
« Báo cáo năm nay (được phát hành trong Báo cáo hàng tuần về Bệnh tật và Tử vong của CDC [MMWR]) tổng hợp dữ liệu năm 2010 từ FoodNet và cung cấp thước đo tốt nhất về xu hướng bệnh truyền qua thực phẩm từ 1996–2010. Nó xác nhận rằng nhiễm Salmonella không giảm trong 15 năm qua,… » Một trong những khuyến nghị của báo cáo để giảm số ca nhiễm Salmonella là “Tăng cường xét nghiệm phòng thí nghiệm và báo cáo bệnh để nhanh chóng nhận diện các đợt bùng phát và nguyên nhân của chúng »
Phương pháp RambaQUICK™ Salmonella: Nhanh chóng và Đơn giản!
Phương pháp RambaQUICK™ Salmonella được thiết kế nhằm đơn giản hóa quy trình kiểm tra trong khi vẫn duy trì độ nhạy cao trong một phương pháp nuôi cấy thông thường.
1. Bước tăng sinh 2 trong 1 : Nước chấm chọn lọc RambaQUICK™ là sự kết hợp của chức năng tốt nhất được tìm thấy trong cả hai phương pháp tăng sinh truyền thống, RVs và MKTTn. Sau giai đoạn hồi sinh trong BPW, Salmonella nhân lên trong pha tăng trưởng lũy thừa trong nước dùng Salmonella RambaQUICK™ tối ưu, không chỉ cung cấp môi trường dinh dưỡng cao mà còn ức chế sự phát triển của vi hệ cạnh tranh.
- Kết quả âm tính trong 2 ngày,
- Kết quả dương tính trong 3 ngày.
- Một pha tăng sinh chọn lọc,
- Một đĩa nuôi cấy.
4. Đáp ứng yêu cầu ISO 6579 : bằng cách phát hiện Salmonella dương tính với lactose với màu sắc nổi bật trên CHROMagar™ Salmonella Plus.
Thành phần

Tài liệu kỹ thuật
Công bố khoa học
2009
Evaluation of RambaQUICK Salmonella for Rapid Detection of Salmonella from Food Samples
📄 Publication

Xem thêm